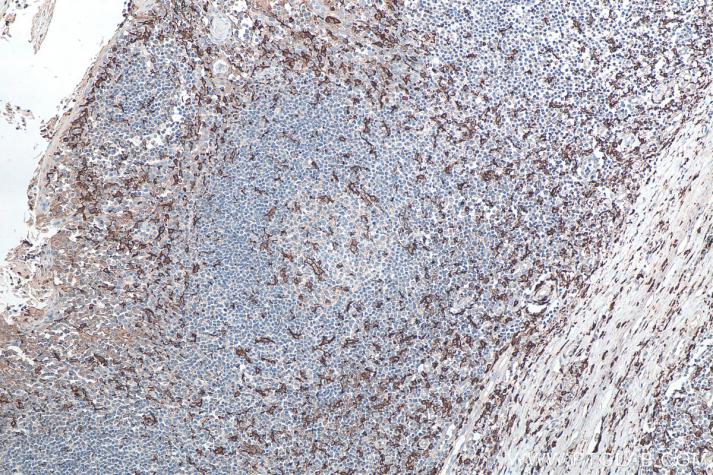

Validation Data Gallery
Product Information
该免疫组化检测试剂盒利用最新的聚合技术将多个过氧化物酶(HRP)分子及抗兔免疫球蛋白二抗偶联到多聚物上,形成的聚合物(二抗)具有放大信号增加敏感度、减少非特异性背景特点。与兔源一抗进行搭配使用,结合后再与DAB反应,可得棕色显色。该反应体系不含生物素和链霉亲和素,不受内源性生物素影响,背景极低;只需要二步反应,即可完成实验过程。同时本试剂盒配有一抗稀释液,可保证抗体的活性和稳定性,减少非特异性结合,降低非特异性背景染色。
注意:如果需要抗原修复液、复染试剂和封片剂,请参阅我们的兔一抗自主全应用免疫组化试剂盒(货号:PK10017)。
产品介绍
组分/规格 | 1 mL | 6 mL | 18 mL | 55 mL | 110 mL |
山羊抗兔 HRP 标记聚合物 | 1 mL | 6 mL | 18 mL | 55 mL | 110 mL |
DAB 原液 20× | 75 uL | 400 uL | 1 mL | 3 mL | 3 mL x 2 |
DAB 稀释液 | 1.5 mL | 8 mL | 20 mL | 60 mL | 120 mL |
一抗稀释液 | 4 mL | 24 mL | 72 mL | 220 mL | 440 mL |
3% H2O2 | 1 mL | 6 mL | 18 mL | 55 mL | 110 mL |
保存条件
该试剂盒应在4℃保存,并在有效期(一年)内使用,切勿冻融。
使用方法
(以石蜡切片染色程序为例)
1) 将石蜡切片脱蜡至水:先将切片置于二甲苯中20分钟,2次。然后依次在100%,95%,80%和60%乙醇,每级放置5分钟。再用蒸馏水浸洗3次,每次1分钟。
2) 抗原修复:根据抗原抗体情况,必要时对切片进行抗原热修复:加入柠檬酸修复液(货号:PR30001)或Tris-EDTA修复液(货号:PR30002)后,将切片放置微波炉,中火修复2次,每次5分钟。结束后在修复液中自然冷却。然后用蒸馏水冲洗3次,每次1分钟。
3) 灭活(可选):根据我们的经验,大多数情况下不需要对内源性过氧化物酶灭活,灭活有时甚至会对染色产生不利影响。然而该步骤在文献中有广泛提及,因此我们依然在该试剂盒中提供了内源性过氧化物酶灭活试剂。
3.1 用 1x 洗涤缓冲液清洗载玻片。沥去载玻片上的液体,并用吸水纸吸干组织切片周围残留的液体(使载玻片玻璃面尽可能干燥)。使用疏水性免疫组化笔(货号:PR30013)在组织切片周围的载玻片上画一个圆圈(可选)。
3.2 取 30-80 uL(依据组织大小)即用型3% H2O2涂在载玻片上,覆盖整个组织。将载玻片在室温下放置 10 分钟。阻断完成后用 1x 洗涤缓冲液清洗载玻片。
4) 封闭:在室温下用封闭缓冲液(例如 3% BSA)封闭组织 30 分钟。沥去载玻片上的液体,并用吸水纸吸干组织切片周围残留的液体。
* 试剂盒中的一抗稀释液也可用作封闭缓冲液的替代品。
5) 孵育一抗:滴加适当一抗稀释液稀释一抗(兔一抗),室温孵育1~2 小时或者4度过夜孵育。TBS冲洗3次,每次1分钟。
6) 孵育二抗:滴加50-100 uL抗兔HRP标记聚合物,室温孵育30 分钟。反应结束后用TBS冲洗3次,每次1分钟。
7) DAB显色:事先将DAB原液与DAB稀释液按照1:20比例配制本次实验所需要的用量,混匀后避光备用。
滴加配制好的显色剂DAB工作液50-100 uL,室温孵育5-10分钟, 或者镜下控制反应时间。蒸馏水洗涤。
8) 显色后可以使用0.5%CuSO4水溶液浸泡5分钟以增强信号对比度(可选)。
9) 苏木素复染2-3分钟,然后蒸馏水冲洗。
10) 各级酒精(60-100%)脱水,每级5分钟。取出后置于二甲苯5分钟,2次。用封片胶封片、显微镜观察。
注意
1.在抗原修复及后续免疫组化染色过程中都需避免组织切片干燥,保持湿润;
2.良好染色效果的获得很大程度上取决于标本制备和正确的实验方法,建议每批实验设置阴阳性对照;
3.本试剂盒一抗稀释液不能用于HRP标记一抗或者二抗的稀释;
4.DAB工作液配制好后需避光保存,且最好在30min内用完;
5.本说明书所提供的操作方法仅供参考,如遇特殊情况需要根据实际情况进行调整。
Publications
| Application | Title |
|---|---|
Chem Biol Interact Targeting PKM2 improves the gemcitabine sensitivity of intrahepatic cholangiocarcinoma cells via inhibiting β-catenin signaling pathway | |
Front Immunol Direct Inhibition of GSDMD by PEITC Reduces Hepatocyte Pyroptosis and Alleviates Acute Liver Injury in Mice. | |
Bioengineered Rapamycin ameliorates chronic intermittent hypoxia and sleep deprivation-induced renal damage via the mammalian target of rapamycin (mTOR)/NOD-like receptor protein 3 (NLRP3) signaling pathway. | |
Biomater Adv Injectable tissue-engineered human cartilage matrix composite fibrin glue for regeneration of articular cartilage defects | |
Mol Cell Biochem RBM15-mediated the m6A modification of MAT2A promotes osteosarcoma cell proliferation, metastasis and suppresses ferroptosis |